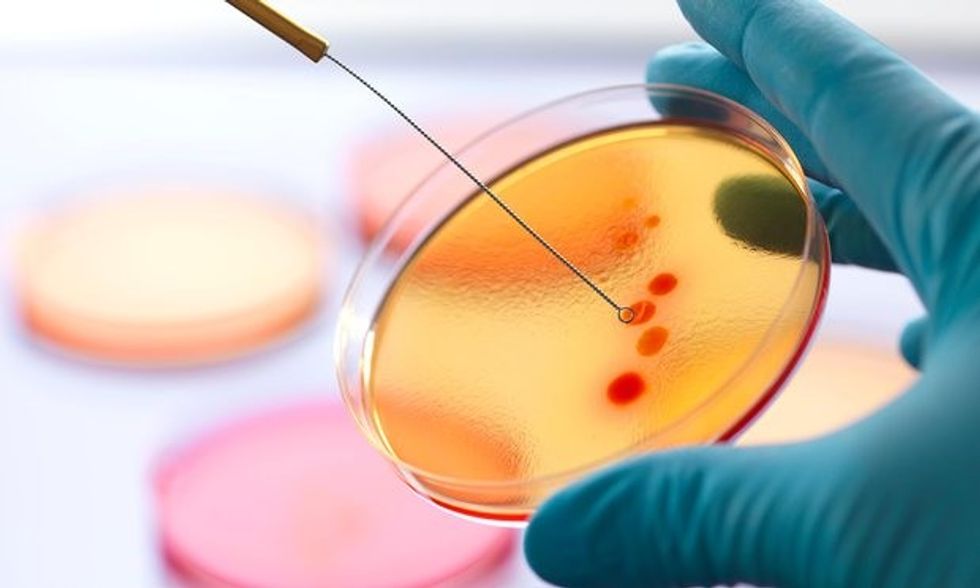
_6958646

Rezistenca ndaj antibiotikëve "do të vrasë më shumë se kanceri"

Rezistenca ndaj antibiotikeve pritet që të vret më shumë se kanceri ka deklaruar mbrëmë politikani britanez, George Osborne.
Në mungesë të ilaçeve të reja, infeksionet e shpeshta do të jenë përgjegjëse për vdekjen e miliona njerëzve në vit deri në 2050-tën, që është më shumë se vdekjet e tanishme nga kanceri që janë 8 milion në vit.
Përveç ndikimit shëndetësor, mungesa e medikamenteve adekuate, do të ketë edhe pasoja ekonomike, deklaroi Osborne, shkruan Daily Mail.
Në fjalimin e tij tek Fondi Monetarë Ndërkombëtare në Uashington, ka theksuar nevojën urgjente për zhvillimin e antibiotikeve të rinj, njëkohësisht ka bërë thirrje për shtetet që të ofrojnë çmime milionëshe për kompanitë farmaceutike të cilat krijojnë ilaçe të reja.
Përdorimi i shpeshtë i antibiotikëve ka ulur efektivitetin e tyre si dhe ka bërë që bakteret të jenë më rezistente.
Ekspertë mjekësorë kanë paralajmëruar për një të ardhme katastrofike ku infeksionet e rëndomta do të jenë vdekjeprurëse, ashtu siç ishin para zbulimit të penicilinës në vitet e 20-ta.
Kjo mund të çoj në një situatë ku lëndimet më të lehta si dhe operacionet të përfundojnë me fatalitet.
Kanë kaluar përafërsisht dy dekada që nga zbulimi i një klase të re antibiotikësh. /Telegrafi/